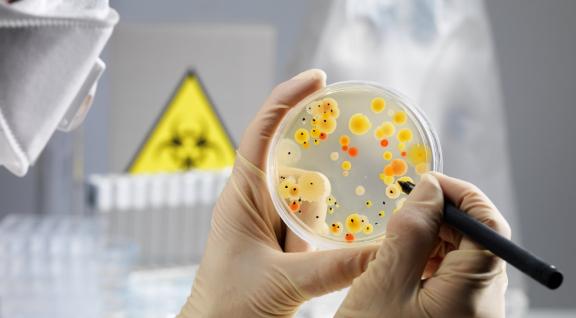

Consultation concept EU guidelines export control for institutions - new date
On October 20, the European Commission published the draft directive for export control in the field of dual-use research.

On October 20, the European Commission published the draft directive for export control in the field of dual-use research.

Instead of the Biosecurity Knowledge Day, the Biosecurity Office is organizing a series of webinars this year. The theme of these webinars is "Biosecurity in Research".
With the current pandemic of COVID-19, there is a great appeal to laboratories for processing sample materials, diagnostics, but also research into a vaccine against SARS-CoV-2.

The International Expert Group of Biosafety and Biosecurity Regulators (IEGBBR) has developed a mobile application that bundles relevant aspects for a biosafety and biosecurity policy.

The Biosecurity Office regularly attends meetings abroad with the aim of sharing knowledge, obtaining knowledge and networking.
